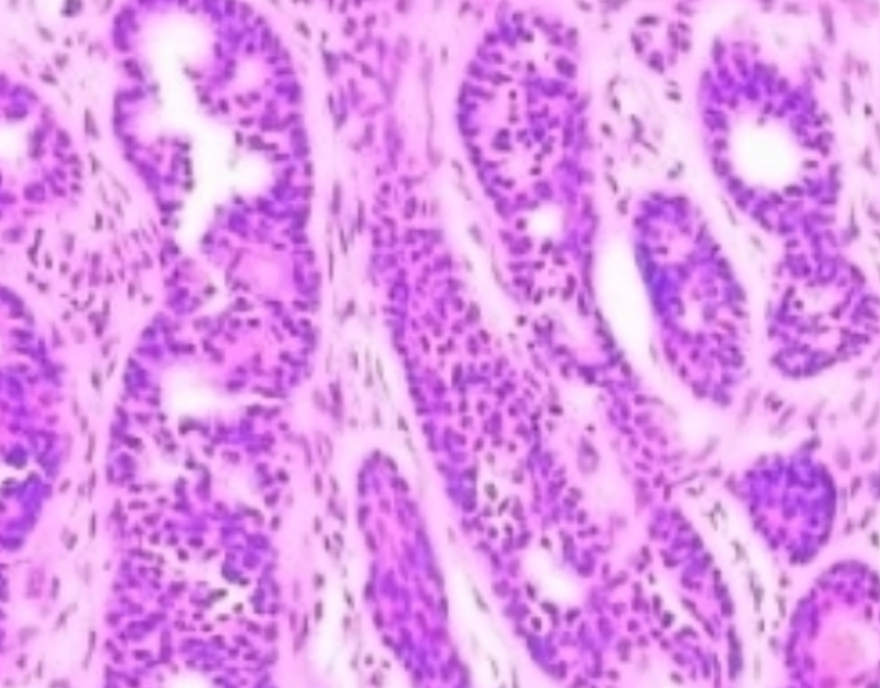
小鼠脑组织免疫组化实验
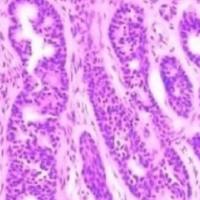
大鼠脑组织免疫组化实验

万千商家帮你免费找货
0 人在求购买到急需产品
- 详细信息
- 技术资料
- 提供商:
上海达为科生物科技有限公司
- 服务名称:
免疫组化实验
一、实验目的
免疫组织化学(Immunohistochemistry,IHC)的基本原理是利用抗原与抗体特异性结合的特性,通过化学反应使标记抗体的显色剂显色来确定组织或细胞内抗原的位置和表达水平。在小鼠脑组织中,IHC 可用于检测特定蛋白在脑区中的分布、神经细胞或胶质细胞的标记、疾病模型中相关蛋白的表达变化等诸多方面,比如研究神经退行性疾病中小鼠脑内 β - 淀粉样蛋白(Aβ)的沉积部位及程度,或是探究某些神经递质受体在小鼠不同脑区神经元中的表达情况等。
二、实验材料
-
实验动物
-
健康小鼠(根据实验需求选择合适品系、年龄等),如 C57BL/6 小鼠等。
-
-
试剂与耗材
-
4% 多ju甲醛(用于组织固定)
-
30% 蔗糖溶液(用于组织脱水)
-
一抗(针对目标蛋白的特异性抗体,需根据研究目的选择合适的宿主动物来源及克隆号等,如抗 NeuN 抗体用于标记神经元,抗 GFAP 抗体用于标记星形胶质细胞等)
-
二抗(与一抗宿主动物对应的荧光或酶标记二抗,如辣根过氧化物酶标记的羊抗鼠二抗等)
-
DAB 显色试剂盒(用于抗体结合位点的显色)
-
封片剂(如甘油 - 缓冲盐溶液等)
-
组织包埋盒、载玻片、盖玻片、手术器械、冰冻切片机或石蜡切片机(根据固定方式和切片要求选择)、振荡器等。
-
三、实验步骤
-
小鼠脑组织固定
-
首先对小鼠进行麻醉,可通过腹腔注射戊ba比妥钠等麻醉剂,确保小鼠处于无痛状态。
-
然后进行灌注固定,打开小鼠胸腔,将导管插入主动脉,先用生理盐水快速灌注以冲净血液,再换用 4% 多ju甲醛进行灌注,直至小鼠肢体变僵硬,脑组织固定良好。
-
取出固定好的脑组织,置于 4℃ 含 4% 多ju甲醛的磷酸盐缓冲液(PBS)中后固定 2 - 4 小时。
-
-
组织脱水与包埋(以冰冻切片为例)
-
将固定后的脑组织放入 30% 蔗糖溶液中,4℃ 振荡脱水,直至脑组织沉底,一般需要 24 - 48 小时,期间可更换蔗糖溶液 1 - 2 次。
-
取出脑组织,用滤纸吸干表面水分,放入组织包埋盒中,加入适量 OCT 包埋剂,迅速放入液氮中冷冻,使其固定成块,便于后续切片。
-
-
切片
-
将包埋好的脑组织置于冰冻切片机上,设置切片厚度(通常为 8 - 20μm,根据研究目的和目标蛋白分布特点而定),切取连续或间隔切片,将切好的片子贴在载玻片上,编号待用。
-
-
脱片与抗原修复(如有需要)
-
若是石蜡切片,则需先进行脱蜡处理,将切片放入二甲苯中脱蜡 2 次,每次 10 - 15 分钟,再依次放入 100%、95%、75%、50% 乙醇中脱水,最后用 PBS 洗涤。
-
对于某些抗原表位在固定过程中可能被掩盖的情况,需进行抗原修复。可采用热修复法,将切片放入 citrate 修复液(pH6.0)中,置于微波炉中加热至沸腾,然后保持微沸状态 10 - 15 分钟,自然冷却后用 PBS 洗涤;或采用蛋白酶修复法,用胰蛋白酶等消化处理切片,使抗原表位暴露。
-
-
免疫组化染色
-
阻断非特异性结合 :用 5% 的正常动物血清(如正常羊血清,与二抗宿主动物一致)或 BSA 溶液封闭切片 30 - 60 分钟,以减少抗体与切片非特异性结合产生的背景染色。
-
一抗孵育 :将适量一抗(按说明书推荐的稀释比例,一般为 1:100 - 1:500)滴加在切片上,使抗体充分覆盖组织,放入湿盒中,在 4℃ 过夜孵育(一般 12 - 16 小时),以保证抗体与抗原充分结合。
-
洗涤 :取出切片,用 PBS 洗涤 3 次,每次 5 分钟,去除未结合的一抗。
-
二抗孵育 :滴加相应二抗(按推荐稀释比例,如 1:200 - 1:1000),同样放入湿盒中,在室温下孵育 1 - 2 小时,使二抗与一抗结合。
-
再次洗涤 :用 PBS 洗涤 3 次,每次 5 分钟,以去除未结合的二抗。
-
-
显色与终止反应
-
加入 DAB 显色液,滴加在切片上,显微镜下观察显色情况,一般显色时间为 5 - 15 分钟,当出现明显的棕褐色反应产物时,立即用蒸馏水终止反应,防止过度显色导致背景过深或组织损伤。
-
也可采用荧光染色方法,此时需要使用荧光显微镜观察,但要注意避光操作,防止荧光淬灭。
-
-
复染(可选)
-
为更清晰地观察组织结构,可进行复染。如用苏木素复染细胞核,将切片浸入苏木素染液中染色 1 - 2 分钟,然后用an水分化,使细胞核呈蓝色,再用 PBS 洗涤。
-
-
脱水、透明与封片
-
对于 DAB 显色后的切片,依次放入 50%、75%、95%、100% 乙醇中脱水,每次 3 - 5 分钟,再放入二甲苯中透明 2 次,每次 5 - 10 分钟。
-
用封片剂封片,将盖玻片轻轻放置在切片上,避免产生气泡,以便后续显微镜观察和长期保存。
-
四、实验结果观察与分析
-
显微镜观察
-
使用光学显微镜或荧光显微镜(针对荧光染色)对染色后的切片进行观察,从低倍镜(如 4×、10×)到高倍镜(40×、100×)逐步观察,确定目标蛋白在小鼠脑组织中的定位、分布区域、细胞类型(如神经元胞体、轴突、树突,胶质细胞等)以及表达强度等情况。
-
-
图像采集与处理
-
通过显微镜配备的摄像头或图像采集系统,拍摄具有代表性的视野图像,采集时注意保持合适的曝光度和对比度,以清晰展示染色信号和组织结构。采集后的图像可使用专业图像分析软件(如 ImageJ 等)进行分析,如测量阳性细胞的面积、密度,统计阳性细胞的数量等,以定量评估目标蛋白的表达水平。
-
-
结果分析与解释
-
根据实验目的和图像分析结果,分析目标蛋白在小鼠脑组织中的表达特点。例如,若研究某种神经保护蛋白在脑缺血模型小鼠脑组织中的变化,对比模型组与对照组的免疫组化结果,若模型组该蛋白表达显著下调,且主要出现在受损脑区神经元内,则提示该蛋白可能在脑缺血损伤中具有重要作用,其表达下调与神经元损伤相关,为进一步探究其机制及干预策略提供依据。
-
风险提示:丁香通仅作为第三方平台,为商家信息发布提供平台空间。用户咨询产品时请注意保护个人信息及财产安全,合理判断,谨慎选购商品,商家和用户对交易行为负责。对于医疗器械类产品,请先查证核实企业经营资质和医疗器械产品注册证情况。
技术资料暂无技术资料 索取技术资料
小鼠脑组织免疫组化实验
询价